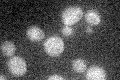
YDR153C
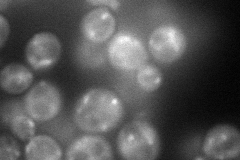
YDR153C
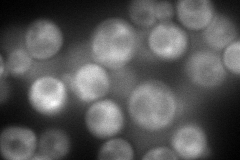
YDR153C
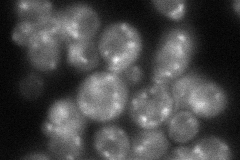
YDR153C
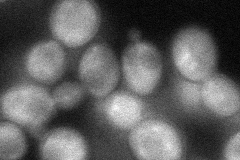
YDR153C
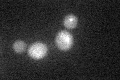
YDR153C

View description
Protein containing an N-terminal epsin-like domain involved in clathrin recruitment and traffic between the Golgi and endosomes; associates with the clathrin adaptor Gga2p, clathrin adaptor complex AP-1, and clathrin
Localization:
Intensity:
Fold change:
Significance:
-
C’ GFP library in SD
below threshold17.37 -
N' NOP1pr-GFP in SD
punctate89.3799 -
N' TEF2pr-mCherry in SD
cytosol,punctate144.025 -
N' NATIVEpr-GFP in SD
punctate70.2628 -
N' TEF2pr-VC and Cyto-VN in SD
cytosol49.9894 -
C’ GFP library in SD+DTT
cytosol15.540.89No -
C’ GFP library in SD+H2O2

cytosol16.910.97No -
C’ GFP library in Starvation Media

cytosol14.410.82No -
C’ GFP library on the background of Pup2-DaMP

below threshold -
C’ GFP library on the background of CCT mutant

below threshold17.23270.991443No
